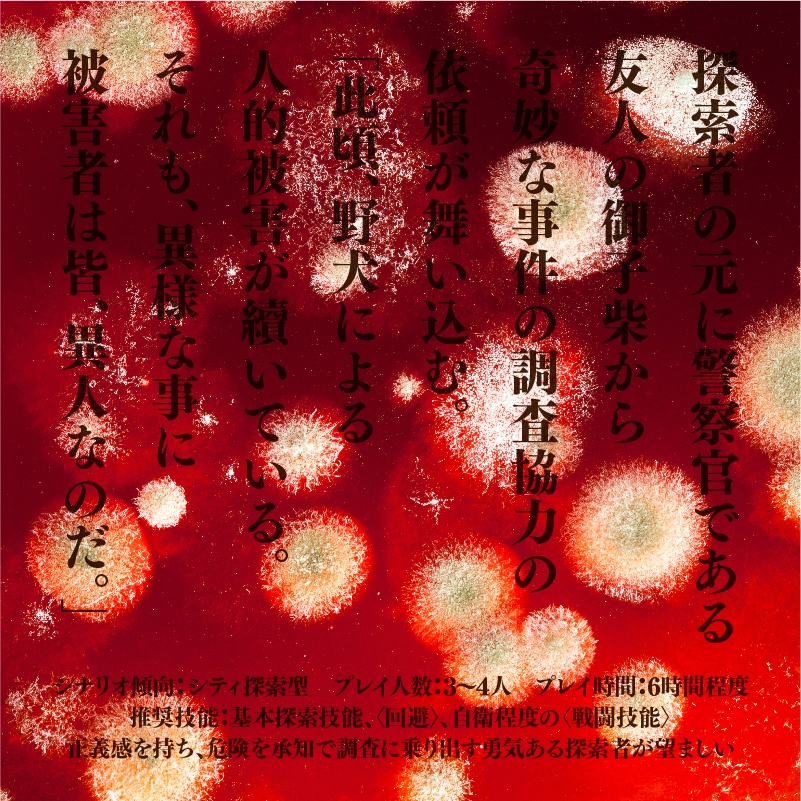
大正CoC「伊呂波区異人連続襲撃事件」
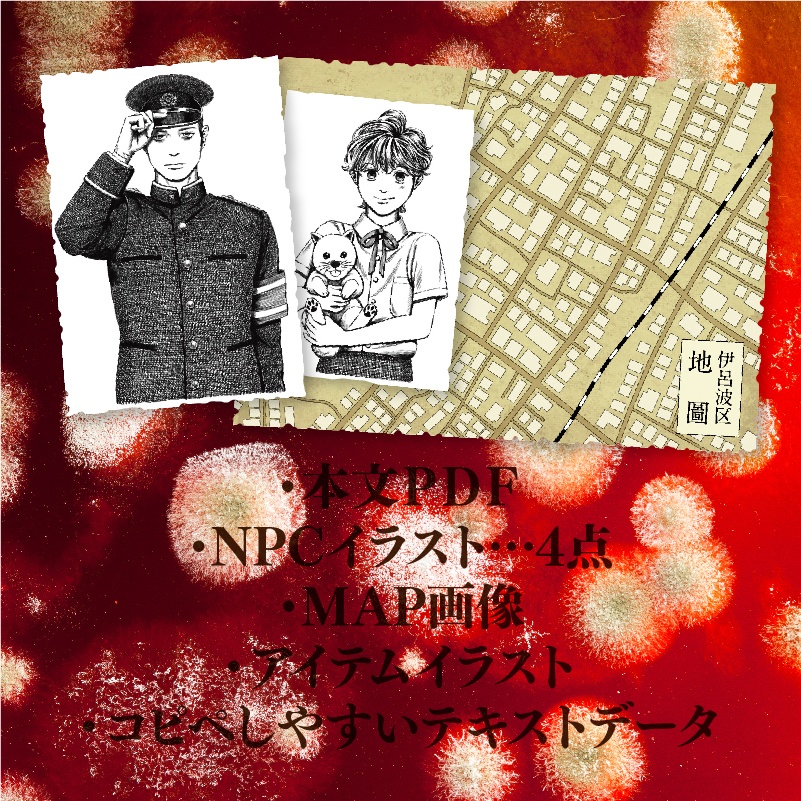
大正CoC「伊呂波区異人連続襲撃事件」

大正CoC「伊呂波区異人連続襲撃事件」
- 無料サンプルDigital0 JPY
- ◆ダウンロード版Digital350 JPY
- ◆書籍版Ships within 14 daysOut of StockShips by Anshin-BOOTH-PackPhysical (direct)1,200 JPY
- ◇イベント会場購入者用DLデータ(パスワードつき)Digital0 JPY

このシナリオは、「クトゥルフ神話TRPG(第6版)」に対応したシナリオである。 第7版でプレイする場合は適宜調整の上プレイすること。 大正〜昭和初期(1920年〜1930年)の日本を舞台としているため、サプリメント「クトゥルフと帝国」があるとより一層楽しめるだろう。大正・昭和初期について調査の上執筆しているが、年代を限定しているわけではない。また、様々な文献・資料を参考にし、シナリオ内に反映させているが、素人による調べであるため、粗や間違いがある可能性がある。予めご了承いただき、大正・昭和初期の日本の雰囲気をざっくりと堪能していただければ幸いである。 探索者は警察官の友人である御子柴 潤一郎から奇妙な事件の調査を依頼され、探索に乗り出すこととなる。 御子柴は探索者にとって信頼のおける友人である。正義感を持ち、危険を承知で探索に乗り出す勇気ある探索者を選出すること。 クラシックなシティ探索型シナリオとなっているので、〈基本探索技能〉〈交渉系技能〉が役立つ。 また、〈戦闘技能〉〈回避〉を習得していると生存率が上がるだろう。 ※このシナリオはフィクションであり、特定の人種、職業、病気等を養護、または非難する目的で作成された物ではない。 ※このシナリオは「狂犬病」という実在の病気を題材として取り扱っている。そのため、犬に対する残酷な表現や、過去に日本で実際に発生した狂犬病に関する事件を元にした表現が一部されている。 KP・PL共に、上記を理解と了承の上、真摯にシナリオに挑んでいただけると幸いである。 ---------------------------------------------- システム:クトゥルフ神話TRPG(第6版) プレイ人数:3~4人 プレイ時間:オフラインセッション、オンラインボイスセッションで5〜6時間 シナリオ傾向:大正昭和初期。シティ探索型。謎解き要素無し。情報を拾っていけば解決できるように作成しています。 ロスト:有り ※サプリメント「クトゥルフと帝国」が無くても遊べます。 ---------------------------------------------- 著者:みゃまらとほてぷ 共著:にしきわずか イラスト:にごり
◆ダウンロード版内容
00_本文PDF 01_トレーラー画像 02_NPCイラスト 03_MAP画像 04_アイテム画像 05_テキストデータ
◆書籍版内容
・CoCシナリオ「伊呂波区異人連続襲撃事件」(B5/表紙カラー/本文白黒/無線綴じ) ・NPCイラスト(名刺サイズ/4種) ・地図(B5サイズ/1種) ・その他諸々 ・ダウンロード版一式(書籍版ご購入の方はダウンロード版も一緒についてきます!)
シナリオ利用規約
1.「いい肉にこにこ」のシナリオは個人的に作られた非公式のものです。各原作者様・各出版社様とは一切関係ありません。 2. 本シナリオの無断転載・複製・複写・自作発言「いい肉にこにこ」以外によるインターネット上への掲載(SNS・ネットオークション・フリマアプリ含む) は固くお断りいたします。 3.「いい肉にこにこ」に対する誹謗中傷や悪質な嫌がらせ行為等が発生した場合は然るべき措置を取ります。 4.「いい肉にこにこ」のシナリオの改変に関しては、KP さんが回しやすいように、また、卓に合わせて臨機応変に改変していただいて良いものとします。 ただし、原形を留めないほどの改変(NPC の性格や設定をほとんど変えてしまう(シナリオ内で変更を許可している場合を除く)、結末やエンディングを全く違うものにする等)は禁止いたします。 5.「いい肉にこにこ」のシナリオのリプレイ作品の作成(動画・小説・漫画等)は許可しています。その際、必ず下記のことをお守り下さい。 ・未プレイの方に配慮する(ネタバレ等に気をつける) ・作者名(いい肉にこにこ)をわかる場所に明記する ・BOOTHの商品ページへのリンクを記載する ・改変されている場合は必ずその旨の明記する ・リプレイ作品を利用するにあたり金銭が発生する場合は事前にご相談ください 7.「いい肉にこにこ」のシナリオを使用した動画配信に関しましては、無償で視聴できる場合のみ許可します。有料会員チャンネルでの配信やスパチャ機能等、金銭が発生する場合は事前にご相談ください。 8. 感想を話したいときはネタバレに配慮し、ふせったーやプライベッターなどをご活用ください。 9. シナリオに同梱されているデータは、私的利用の範囲内でご利用ください。 (してもいいことの例) ◯ココフォリア等のオンラインセッションツールにアップロードし使用する ◯印刷・コピーし、オフラインセッションで使用する ◯トレーラー画像を卓募集の際にSNS に投稿する ◯配信やリプレイ動画に同梱データを使用する (してはいけないことの例) ×同梱データを使用しセッション目的以外のものを制作する ×同梱データを複数人に譲渡する(サブキーパーに見せるため、5人以下の少人数グループでお金を出し合って購入した場合はこの限りではありません) ×トレーラー以外の同梱データをSNS上にアップロードする(ネタバレにあたりますのでご遠慮ください)


